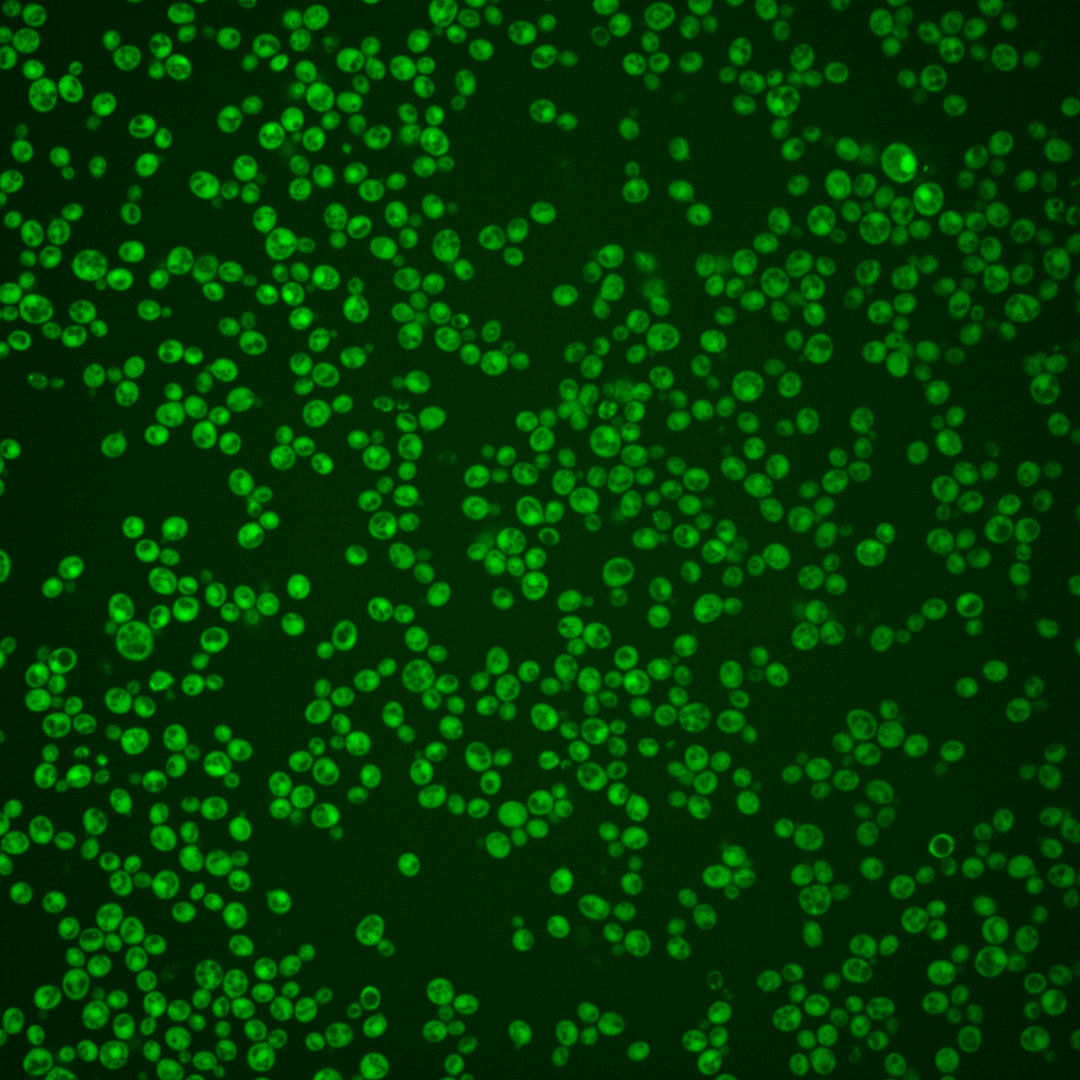
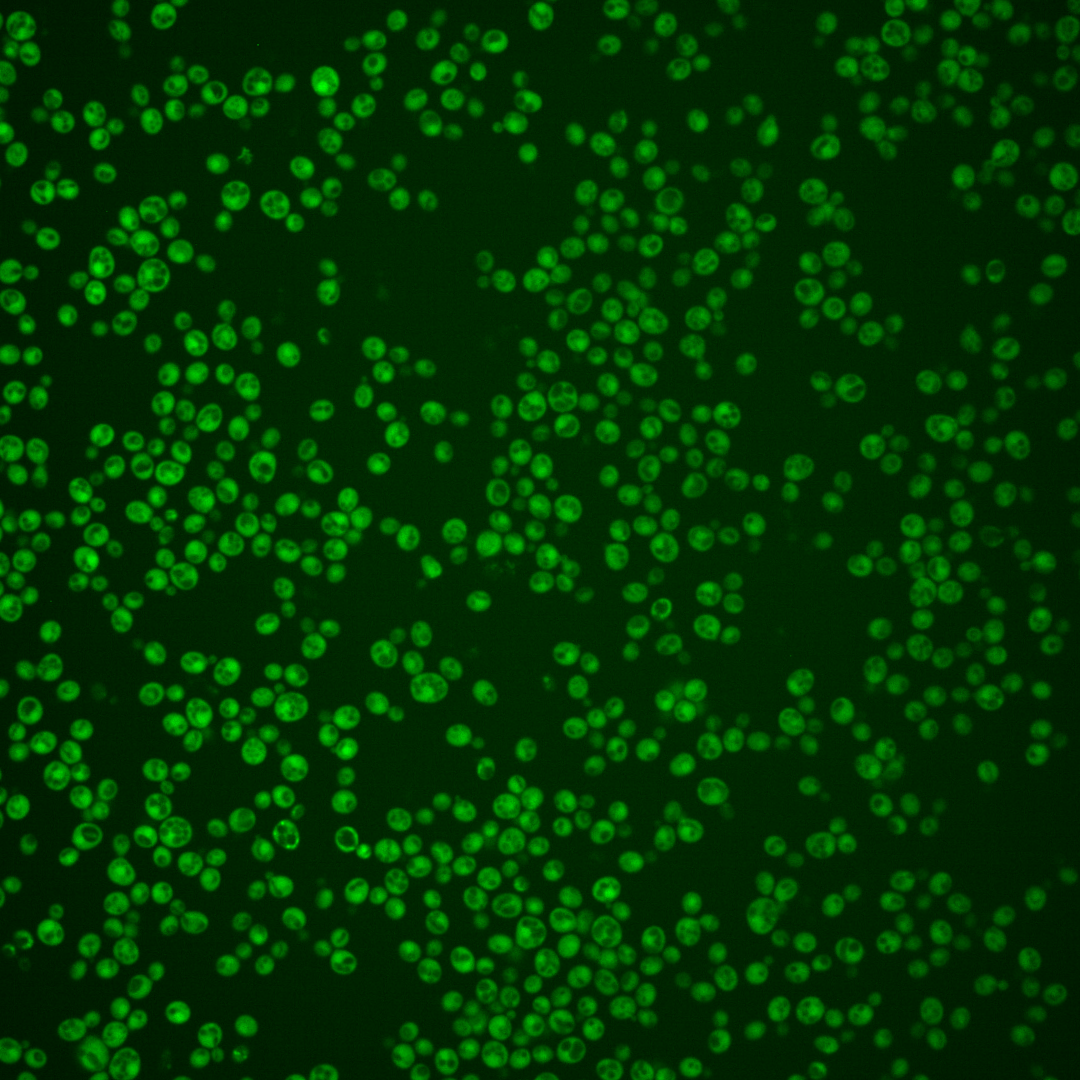
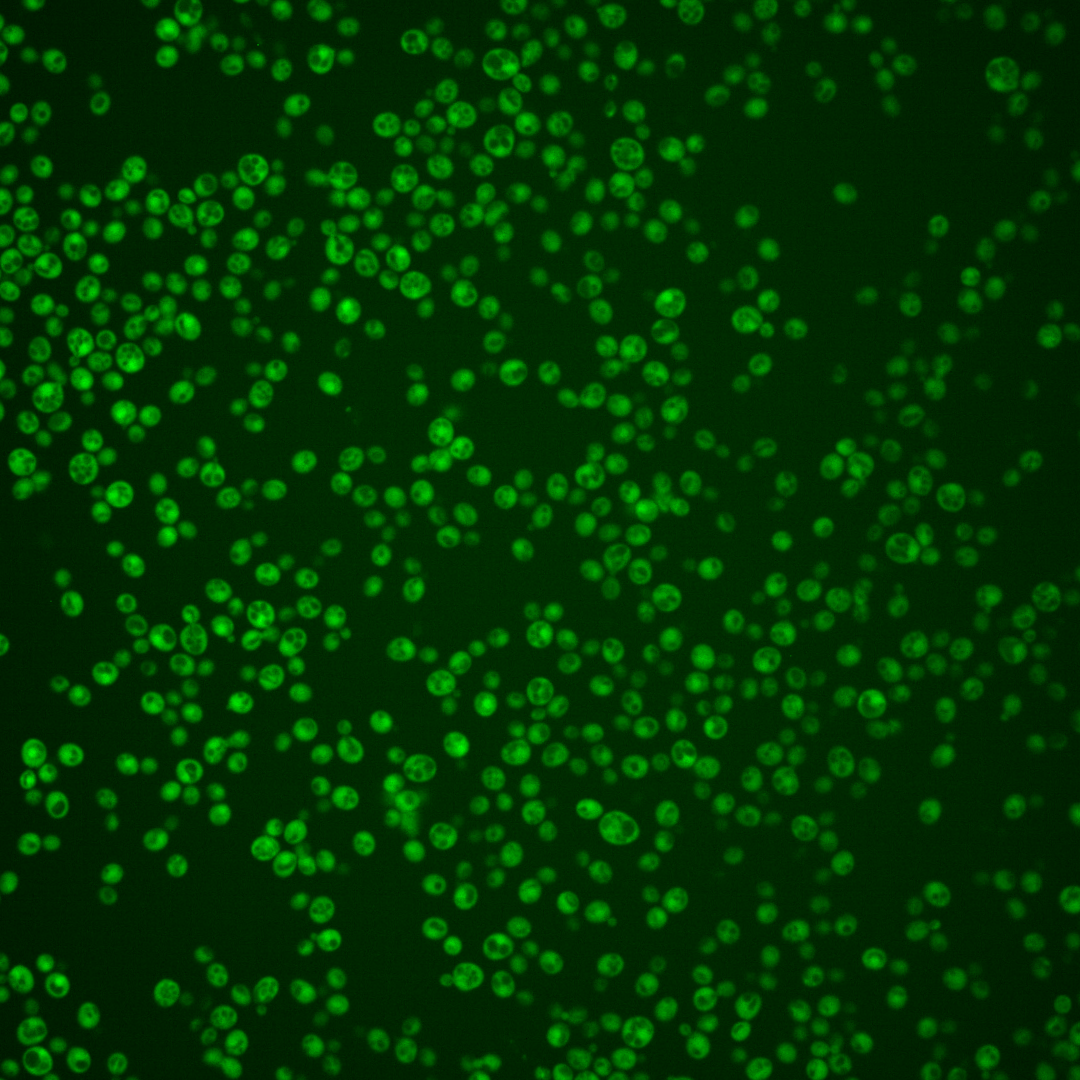

| ORF | |
|---|---|
| Human Ortholog | |
| Description | Putative protein of unknown function; conserved among S. cerevisiae strains |
Micrographs




















































































Sub-cellular Localization
Yeast GFP Assignment
Protein Abundance
Localization Change
External localization resources
| ensLOC | DeepLoc | |||||||||||||||||||||||
|---|---|---|---|---|---|---|---|---|---|---|---|---|---|---|---|---|---|---|---|---|---|---|---|---|
| Localization | WT1 | WT2 | WT3 | RAP60 | RAP140 | RAP220 | RAP300 | RAP380 | RAP460 | RAP540 | RAP620 | RAP700 | HU80 | HU120 | HU160 | rpd3Δ_1 | rpd3Δ_2 | rpd3Δ_3 | WT1 | WT2 | WT3 | AF100 | AF140 | AF180 |
| Cortical Patches | 0 | 0 | 0 | 0 | 0 | 0 | – | 0 | 0 | 0 | 0 | 0 | 0 | 0 | 0 | 0 | 0 | 0 | 0 | 0 | 1 | 0 | 0 | 1 |
| Bud | 1 | 1 | 4 | 0 | 0 | 2 | – | 4 | 7 | 6 | 12 | 15 | 1 | 2 | 1 | 0 | 0 | 0 | 0 | 0 | 0 | 0 | 0 | 0 |
| Bud Neck | 0 | 0 | 0 | 0 | 0 | 0 | – | 0 | 0 | 0 | 0 | 0 | 0 | 0 | 0 | 0 | 0 | 0 | 0 | 0 | 0 | 0 | 0 | 0 |
| Bud Site | 0 | 0 | 0 | 0 | 0 | 0 | – | 1 | 0 | 1 | 1 | 1 | 0 | 0 | 0 | 0 | 0 | 0 | – | – | – | – | – | – |
| Cell Periphery | 1 | 1 | 0 | 0 | 4 | 0 | – | 3 | 3 | 3 | 7 | 11 | 3 | 2 | 6 | 2 | 0 | 1 | 0 | 0 | 0 | 0 | 0 | 0 |
| Cytoplasm | 431 | 211 | 115 | 304 | 472 | 340 | – | 511 | 346 | 490 | 375 | 498 | 204 | 494 | 499 | 22 | 19 | 68 | 420 | 196 | 119 | 69 | 222 | 276 |
| Endoplasmic Reticulum | 1 | 1 | 0 | 0 | 2 | 0 | – | 1 | 0 | 7 | 0 | 1 | 1 | 1 | 2 | 0 | 2 | 1 | 0 | 0 | 0 | 0 | 1 | 1 |
| Endosome | 0 | 0 | 0 | 0 | 1 | 1 | – | 0 | 0 | 2 | 0 | 0 | 0 | 1 | 0 | 0 | 0 | 0 | 2 | 1 | 1 | 0 | 3 | 4 |
| Golgi | 0 | 1 | 0 | 0 | 1 | 0 | – | 0 | 0 | 0 | 0 | 0 | 0 | 2 | 0 | 0 | 0 | 0 | 0 | 1 | 0 | 0 | 1 | 1 |
| Mitochondria | 2 | 1 | 6 | 14 | 14 | 80 | – | 192 | 197 | 258 | 257 | 355 | 1 | 1 | 0 | 0 | 0 | 1 | 2 | 0 | 1 | 0 | 2 | 2 |
| Nucleus | 4 | 2 | 1 | 1 | 2 | 3 | – | 15 | 9 | 12 | 8 | 8 | 1 | 3 | 1 | 0 | 0 | 0 | 0 | 1 | 0 | 1 | 0 | 0 |
| Nuclear Periphery | 0 | 0 | 0 | 0 | 0 | 0 | – | 4 | 3 | 5 | 1 | 6 | 0 | 1 | 0 | 0 | 0 | 1 | 0 | 0 | 0 | 0 | 0 | 0 |
| Nucleolus | 0 | 0 | 0 | 0 | 1 | 1 | – | 1 | 1 | 0 | 0 | 1 | 0 | 2 | 0 | 0 | 0 | 1 | 0 | 0 | 0 | 0 | 0 | 0 |
| Peroxisomes | 0 | 0 | 0 | 0 | 0 | 0 | – | 0 | 0 | 0 | 0 | 0 | 0 | 0 | 0 | 0 | 0 | 0 | 0 | 0 | 0 | 0 | 0 | 0 |
| SpindlePole | 0 | 0 | 0 | 0 | 0 | 0 | – | 0 | 0 | 1 | 0 | 0 | 0 | 0 | 0 | 0 | 0 | 0 | 1 | 1 | 0 | 0 | 0 | 0 |
| Vac/Vac Membrane | 1 | 1 | 0 | 0 | 16 | 5 | – | 44 | 35 | 31 | 25 | 16 | 0 | 3 | 0 | 2 | 0 | 1 | 1 | 5 | 2 | 2 | 3 | 2 |
| Unique Cell Count | 434 | 214 | 120 | 306 | 490 | 375 | 678 | 484 | 701 | 539 | 724 | 205 | 503 | 502 | 23 | 19 | 70 | 435 | 209 | 129 | 77 | 239 | 295 | |
| Labelled Cell Count | 441 | 219 | 126 | 319 | 513 | 432 | 776 | 601 | 816 | 686 | 912 | 211 | 512 | 509 | 26 | 21 | 74 | 435 | 209 | 129 | 77 | 239 | 295 | |
Yeast GFP Assignment
Protein Abundance
| Screen | WT1 | WT2 | WT3 | RAP60 | RAP140 | RAP220 | RAP300 | RAP380 | RAP460 | RAP540 | RAP620 | RAP700 | HU80 | HU120 | HU160 | rpd3Δ_1 | rpd3Δ_2 | rpd3Δ_3 | AF100 | AF140 | AF180 |
|---|---|---|---|---|---|---|---|---|---|---|---|---|---|---|---|---|---|---|---|---|---|
| Mean Cell GFP Intensity (1e-4) | 8.0 | 9.2 | 4.9 | 6.2 | 6.6 | 5.0 | – | 4.6 | 4.1 | 4.3 | 4.0 | 3.9 | 8.8 | 9.1 | 8.7 | 9.7 | 9.2 | 9.3 | 7.4 | 9.1 | 9.5 |
| Std Deviation (1e-4) | 1.1 | 1.2 | 0.8 | 1.0 | 1.6 | 1.0 | – | 0.9 | 0.9 | 0.9 | 0.7 | 0.8 | 1.2 | 1.1 | 1.0 | 1.3 | 1.0 | 1.7 | 1.0 | 1.4 | 1.4 |
| Intensity Change (Log2) | – | – | – | 0.36 | 0.44 | 0.05 | – | -0.07 | -0.25 | -0.19 | -0.29 | -0.32 | 0.85 | 0.91 | 0.84 | 0.99 | 0.92 | 0.94 | 0.61 | 0.9 | 0.96 |
Localization Change
| Localization | RAP60 | RAP140 | RAP220 | RAP300 | RAP380 | RAP460 | RAP540 | RAP620 | RAP700 | HU80 | HU120 | HU160 | rpd3Δ_1 | rpd3Δ_2 | rpd3Δ_3 |
|---|---|---|---|---|---|---|---|---|---|---|---|---|---|---|---|
| Cortical Patches | 0 | 0 | 0 | – | 0 | 0 | 0 | 0 | 0 | 0 | 0 | 0 | 0 | 0 | 0 |
| Bud | 0 | 0 | 0 | – | 0 | 0 | 0 | 0 | 0 | 0 | 0 | 0 | 0 | 0 | 0 |
| Bud Neck | 0 | 0 | 0 | – | 0 | 0 | 0 | 0 | 0 | 0 | 0 | 0 | 0 | 0 | 0 |
| Bud Site | 0 | 0 | 0 | – | 0 | 0 | 0 | 0 | 0 | 0 | 0 | 0 | 0 | 0 | 0 |
| Cell Periphery | 0 | 0 | 0 | – | 0 | 0 | 0 | 0 | 0 | 0 | 0 | 0 | 0 | 0 | 0 |
| Cytoplasm | 2.6 | 0.3 | -1.8 | – | -5.0 | -5.6 | -6.0 | -6.0 | -6.2 | 2.4 | 1.6 | 3.1 | 0 | 0.9 | 0.5 |
| Endoplasmic Reticulum | 0 | 0 | 0 | – | 0 | 0 | 0 | 0 | 0 | 0 | 0 | 0 | 0 | 0 | 0 |
| Endosome | 0 | 0 | 0 | – | 0 | 0 | 0 | 0 | 0 | 0 | 0 | 0 | 0 | 0 | 0 |
| Golgi | 0 | 0 | 0 | – | 0 | 0 | 0 | 0 | 0 | 0 | 0 | 0 | 0 | 0 | 0 |
| Mitochondria | -0.2 | 0 | 4.1 | – | 0 | 0 | 0 | 0 | 0 | 0 | 0 | 0 | 0 | 0 | 0 |
| Nucleus | 0 | 0 | 0 | – | 0 | 0 | 0 | 0 | 0 | 0 | 0 | 0 | 0 | 0 | 0 |
| Nuclear Periphery | 0 | 0 | 0 | – | 0 | 0 | 0 | 0 | 0 | 0 | 0 | 0 | 0 | 0 | 0 |
| Nucleolus | 0 | 0 | 0 | – | 0 | 0 | 0 | 0 | 0 | 0 | 0 | 0 | 0 | 0 | 0 |
| Peroxisomes | 0 | 0 | 0 | – | 0 | 0 | 0 | 0 | 0 | 0 | 0 | 0 | 0 | 0 | 0 |
| SpindlePole | 0 | 0 | 0 | – | 0 | 0 | 0 | 0 | 0 | 0 | 0 | 0 | 0 | 0 | 0 |
| Vacuole | 0 | 0 | 0 | – | 2.9 | 3.0 | 0 | 0 | 0 | 0 | 0 | 0 | 0 | 0 | 0 |
External localization resources
Images






























Protein Concentration and Protein Localization Data
| R1 | R2 | R3 | ||||||||||||||||
|---|---|---|---|---|---|---|---|---|---|---|---|---|---|---|---|---|---|---|
| G1 Pre-START | G1 Post-START | S/G2 | Metaphase | Anaphase | Telophase | G1 Pre-START | G1 Post-START | S/G2 | Metaphase | Anaphase | Telophase | G1 Pre-START | G1 Post-START | S/G2 | Metaphase | Anaphase | Telophase | |
| Concentration | 3.4862 | 4.7665 | 4.2953 | 4.023 | 3.2445 | 4.2771 | 3.1703 | 4.6041 | 3.9043 | 3.3013 | 3.6081 | 4.025 | 5.4168 | 7.4682 | 6.4751 | 6.6569 | 5.6487 | 6.3527 |
| Actin | 0.0035 | 0.0003 | 0.0038 | 0.0207 | 0.0015 | 0.0003 | 0.0111 | 0.0003 | 0.0081 | 0.0195 | 0.0043 | 0.0008 | 0.0175 | 0.0003 | 0.0043 | 0.0004 | 0.001 | 0.0034 |
| Bud | 0.0003 | 0.0001 | 0.0005 | 0.0004 | 0.0001 | 0.0001 | 0.0008 | 0.0001 | 0.0002 | 0.0003 | 0.0026 | 0.0001 | 0.0003 | 0.0002 | 0.0002 | 0.0001 | 0.0002 | 0.0001 |
| Bud Neck | 0.0029 | 0.0002 | 0.0005 | 0.0085 | 0.0006 | 0.0007 | 0.002 | 0.0001 | 0.0003 | 0.0009 | 0.0006 | 0.0007 | 0.0081 | 0.0001 | 0.0009 | 0.0005 | 0.0005 | 0.005 |
| Bud Periphery | 0.0003 | 0 | 0.0005 | 0.0006 | 0 | 0 | 0.0012 | 0 | 0.0003 | 0.0003 | 0.0064 | 0.0001 | 0.0002 | 0.0003 | 0.0001 | 0 | 0.0003 | 0.0001 |
| Bud Site | 0.0014 | 0.0006 | 0.0007 | 0.0013 | 0.0003 | 0 | 0.0044 | 0.0005 | 0.0007 | 0.0013 | 0.0021 | 0.0001 | 0.0056 | 0.0005 | 0.0055 | 0.0001 | 0.0004 | 0.0003 |
| Cell Periphery | 0.0001 | 0 | 0.0001 | 0.0003 | 0 | 0 | 0.0003 | 0 | 0.0001 | 0.0001 | 0.0003 | 0 | 0.0002 | 0.0001 | 0.0003 | 0 | 0.0001 | 0 |
| Cytoplasm | 0.9017 | 0.9623 | 0.9463 | 0.9198 | 0.9102 | 0.9661 | 0.8688 | 0.9812 | 0.9316 | 0.9074 | 0.7007 | 0.9211 | 0.8279 | 0.9863 | 0.9422 | 0.9679 | 0.8594 | 0.9467 |
| Cytoplasmic Foci | 0.0202 | 0.006 | 0.0125 | 0.0043 | 0.0286 | 0.0054 | 0.0184 | 0.0051 | 0.0076 | 0.0084 | 0.0345 | 0.0108 | 0.0354 | 0.0015 | 0.0086 | 0.014 | 0.0056 | 0.0056 |
| Eisosomes | 0 | 0 | 0.0001 | 0.0001 | 0 | 0 | 0.0001 | 0 | 0 | 0.0003 | 0.0001 | 0 | 0.0001 | 0 | 0.0001 | 0 | 0 | 0 |
| Endoplasmic Reticulum | 0.006 | 0.0017 | 0.0026 | 0.0045 | 0.0036 | 0.0017 | 0.0063 | 0.0013 | 0.0016 | 0.0009 | 0.0021 | 0.0038 | 0.0047 | 0.0004 | 0.0015 | 0.0009 | 0.0005 | 0.0017 |
| Endosome | 0.0188 | 0.0025 | 0.0058 | 0.0084 | 0.0073 | 0.003 | 0.0163 | 0.0011 | 0.0141 | 0.0052 | 0.0753 | 0.0157 | 0.023 | 0.0003 | 0.0037 | 0.0017 | 0.0147 | 0.0045 |
| Golgi | 0.0034 | 0.0002 | 0.0019 | 0.0013 | 0.0014 | 0.0001 | 0.007 | 0.0001 | 0.0043 | 0.0103 | 0.0228 | 0.0066 | 0.0056 | 0 | 0.0022 | 0.0002 | 0.0113 | 0.0049 |
| Lipid Particles | 0.0028 | 0 | 0.0005 | 0.0003 | 0.0054 | 0 | 0.0139 | 0 | 0.0024 | 0.0117 | 0.0179 | 0.003 | 0.0168 | 0 | 0.0053 | 0 | 0.0464 | 0.0078 |
| Mitochondria | 0.0017 | 0.0001 | 0.0011 | 0.0004 | 0.0004 | 0.0004 | 0.0054 | 0.0001 | 0.012 | 0.0111 | 0.0509 | 0.0113 | 0.0011 | 0.0001 | 0.0028 | 0.0001 | 0.0341 | 0.0041 |
| None | 0.0195 | 0.0197 | 0.0123 | 0.0162 | 0.0037 | 0.0131 | 0.0172 | 0.0068 | 0.0039 | 0.0022 | 0.0035 | 0.0095 | 0.0262 | 0.0075 | 0.0114 | 0.0061 | 0.0015 | 0.0029 |
| Nuclear Periphery | 0.0023 | 0.0008 | 0.0015 | 0.0028 | 0.0029 | 0.001 | 0.0033 | 0.0005 | 0.0009 | 0.0006 | 0.0072 | 0.0025 | 0.003 | 0.0003 | 0.0008 | 0.0005 | 0.0005 | 0.001 |
| Nucleolus | 0.0001 | 0 | 0.0001 | 0.0001 | 0.0001 | 0 | 0.002 | 0 | 0.0002 | 0.0001 | 0.0007 | 0 | 0.0002 | 0 | 0.0001 | 0 | 0.0006 | 0.0001 |
| Nucleus | 0.0051 | 0.0032 | 0.0055 | 0.0068 | 0.0065 | 0.0065 | 0.0043 | 0.002 | 0.0026 | 0.0026 | 0.0056 | 0.0079 | 0.0045 | 0.0017 | 0.0036 | 0.0045 | 0.0024 | 0.0078 |
| Peroxisomes | 0.0043 | 0.0002 | 0.0016 | 0.0001 | 0.0216 | 0.0002 | 0.0047 | 0.0001 | 0.0023 | 0.0157 | 0.0189 | 0.0032 | 0.0135 | 0 | 0.0046 | 0.0004 | 0.0164 | 0.0022 |
| Punctate Nuclear | 0.0029 | 0.0008 | 0.0012 | 0.001 | 0.0046 | 0.0007 | 0.0062 | 0.0003 | 0.0004 | 0.0004 | 0.0079 | 0.0012 | 0.0051 | 0.0002 | 0.0015 | 0.0023 | 0.0003 | 0.0008 |
| Vacuole | 0.0021 | 0.0009 | 0.0007 | 0.0018 | 0.0008 | 0.0005 | 0.0049 | 0.0003 | 0.0041 | 0.0005 | 0.0258 | 0.0009 | 0.0007 | 0.0001 | 0.0003 | 0.0002 | 0.0021 | 0.0004 |
| Vacuole Periphery | 0.0004 | 0.0001 | 0.0002 | 0.0004 | 0.0002 | 0.0001 | 0.0014 | 0 | 0.0022 | 0.0003 | 0.0098 | 0.0006 | 0.0002 | 0 | 0.0001 | 0.0001 | 0.0018 | 0.0003 |
Sequencing Data
| R1 | R2 | |||||||||
|---|---|---|---|---|---|---|---|---|---|---|
| G1 Post-START | S/G2 | Metaphase | Anaphase | Telophase | G1 Post-START | S/G2 | Metaphase | Anaphase | Telophase | |
| Gene Expression | – | – | – | – | – | – | – | – | – | – |
| Translational Efficiency | – | – | – | – | – | – | – | – | – | – |
Hit Data
| Dataset | Hit |
|---|---|
| Protein Concentration | ✘ |
| Protein Localization | ✘ |
| Gene Expression | – |
| Translational Efficiency | – |
Endocytosis
| Temp | Actin Patch (Sac6-tdTomato) | Cortical Patch (Sla1-GFP) | Late Endosome (Snf7-GFP) | Vacuole (Vph1-GFP) |
|---|---|---|---|---|
| 37℃ | ||||
| RT |
Cell Cycle Omics
CYCLoPs (Yel014c-GFP)
| Gene / Allele | Actin Patch (Sac6-tdTomato) | Cortical Patch (Sla1-GFP) | Late Endosome (Snf7-GFP) | Vacuole (Sac6-tdTomato) |
|---|
| Gene | Images |
|---|
| Gene | Images |
|---|
Images are not yet available
Images are not yet available